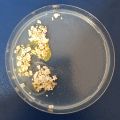

Documentation
22.04.2021
Sample 1:
Sample 2:
23.04.2021
Sample 1:
in the morning i had to remove some white mold and fed them with more oatflakes
Sample 2:
in the morning i had to remove some mold and fed them with more oat flakes
25.4.2021
For the weekend i brought my three samples to my parents house in another city. To transport the Physarum safely in a train I repurposed the tool kit suitcase. It seems like the transportation and change of surrounding has not harmed the organisms. On the contrary, the Physarum is growing faster in the dark suitcase than in a shadowy place in my room.
26.4.2021
The Physarum covers all of the petri-dish now. It is very bright and yellow.
27.4.2021
The Physarum is back in Weimar and this morning it grew out of the petri-dish. Time for a new environment. I prepared a cardbox with baking paper, cooked a lot of agar medium and filled the cardbox with that. I used agar from the supermarket and a cardbox is not a totally serile environment. Will the Physarum still grow?
I would love to imitate a small part of a forest, maybe inside of an aquarium where the Physarum can grow in an environment that is as natural as possible.
Interesting link:
https://www.geo.de/natur/naturwunder-erde/16036-rtkl-schlauer-pilz-dieser-schleimpilz-kann-sich-erinnern-und-raetsel
28.4.2021
The Physarum is growing very fast in the improvised cardboard box environment. Even faster than in the petri dishes.
29.4.2021
30.4.2021
i added coffee grounds and the Physarum seems to like it
1.5.2021
the sample in the petri dishes startet to dry a bit
2.5.2021
3.5.2021
i added some potato peel to try out if the Physarum likes it but it has not been discovered yet
and i startet to grow a sample in the maze
7.5.2021
Reviving some semi-dried Physarum was successful:
9.5.2021
starting to grow a lot of Physarum in a big environment, so i can test out different fabrics:
9.5.-18.5.
ARCHIVE
first experiments:
Growing Physarum on fabric:
- pure fabric
- fabric treated with agar beforehand
--> both fabric samples were placed on agar and then overgrown with Physarum
- samples of Physarum placed on the fabric (can it be revived or is the Physarum sample too weak?)
- fabric placed on Physarum and then overgrown with Physarum (the best reult so far)
In the end, i decided to grow the Physarum on plastic foil which is then placed on the fabric instead of letting the Physarum grow directly on the fabric. After a week the Physarum is dry and the clothing is ready to be worn.
How can Physarum be made into clothes?
The Physarum has to be grown on plastic foil, this works best, when the Physarum spills over from agar to plastic foil in its growing stage. The plastic foil is then placed on the fabric and pressed for about one week under nine books. This will result in a smooth leathery surface on the fabric, the earthy scent is included
Sustainability
Could you think of your project in terms of sustainability? Social, economic, ecological? Could you think of the impact on the “other” bubble? How does your project contribute to the aspects?
Fast fashion is one of the biggest climate killers in terms of water pollution, garbage production and c02 output. The fashion industry needs to focus on regrowing ecological media that does not harm the environment. Physarum can be the suitable medium for this problem. It is fast and cheap to grow and will not pollute or harm nature. After ist use for fashion and clothes it will simply become a part of nature again.
Future experiments
might include: reviving the Physarum when it is dormant on the clothes --> how will it grow when it is worn for a night out?